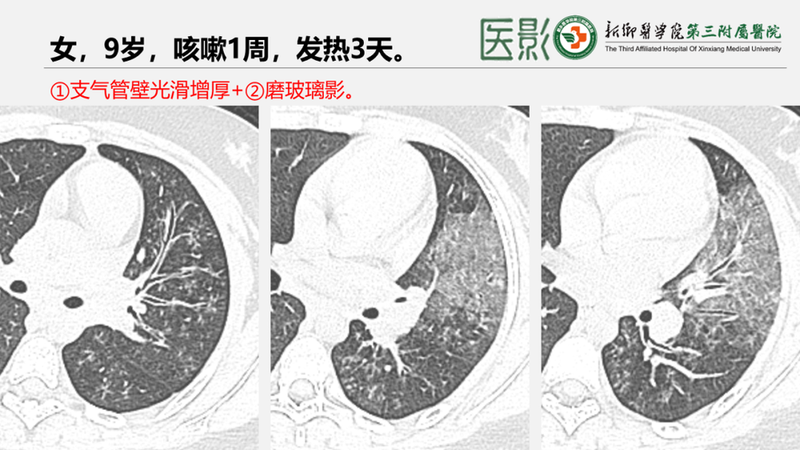
图片

社区获得性肺炎CT诊断系列—支原体肺炎
2024年8月25日
![图片]()
![图片]()
![图片]()
![图片]()
![图片]()
![图片]()
![图片]()
![图片]()
![图片]()
![图片]()
![图片]()
![图片]()
![图片]()
![图片]()
![图片]()
![图片]()
![图片]()
![图片]()
![图片]()
【概述】支原体肺炎(mycoplasmalpneumonia)是由支原体引起的以间质改变为主的肺炎。肺炎支原体较一般细菌小、较病毒大,已知能独立生存的最小微生物,无细胞壁结构。由口、鼻分泌物经空气传播,引起散发性或流行性呼吸道感染,多于冬春及夏秋之交。
【临床】MPP潜伏期为1-3周,发病形式多样,以发热、咳嗽为主要症状。•多数仅以低热、疲乏为主,部分可出现突发高热(可>38°C)并伴有明显的头痛、肌痛及恶心等全身中毒症状。少数重症有高热及呼吸困难。发热时间可长达1-2周。•呼吸道症状以干咳最为突出,多伴有明显咽痛,偶有胸痛、痰中带血,一般咳嗽比较剧烈(干咳最为突出),咳嗽时间多为两周,而且在发热退后咳嗽还可能继续1-2周。部分可无自觉症状。5岁以下儿童患者症状多轻微。•肺外并发症——神经系统、心血管系统及肾损害持续时间较长。•实验室:外周血白细胞总数和中性粒细胞比例一般正常,少数病人可升高。支原体抗体呈阳性,发病后2-3周血冷凝集试验比值升高(可达1:64)。支原体特异性抗体lgM、lgG增高有诊断意义,但早期常阴性。
![图片]()
①树雾征(树芽征+磨玻璃征)——支气管管壁增厚,管腔狭窄,粘液栓在细支气管形成“树芽征”+“磨玻璃征”:肺泡性炎症、实变。⑤磨玻璃征(78%):朦胧的磨砂玻璃影——周围间质充血,炎症。⑨实变(61%) ——间质性疾病引起假性实变,呈斑片状、节段性或非节段性分布,倾向于以肺下部区域为主。⑩病灶往往从肺门向肺野延续(病灶位于支气管周围的缘故)。⑬细支气管炎,可见气道阻塞伴马赛克灌注和呼气性气体滞留(闭塞性细支气管炎); 少数可阻塞小气道形成区域性肺不张(塑性形支气管炎) 。![图片]()
![图片]()
![图片]()
![图片]()
![图片]()
![图片]()
![图片]()
![图片]()
![图片]()
![图片]()
![图片]()
![图片]()
![图片]()
![图片]()
![图片]()
![图片]()
![图片]()
![图片]()
![图片]()
![图片]()
![图片]()
![图片]()